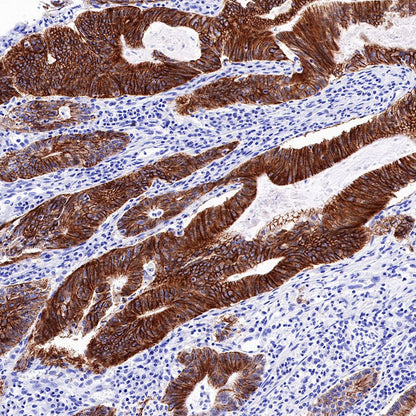

Product Details
Product Details
Product Specification
Host | Rabbit |
Antigen | Cadherin 17 |
Synonyms | Intestinal peptide-associated transporter HPT-1, Liver-intestine cadherin, LI-cadherin |
Immunogen | N/A |
Location | Cell membrane |
Accession | Q12864 |
Clone Number | SDT-R151 |
Antibody Type | Recombinant mAb |
Application | IHC-P, IF |
Reactivity | Hu |
Purification | Protein A |
Concentration | 0.5 mg/ml |
Physical Appearance | Liquid |
Storage Buffer | PBS, 40% Glycerol, 0.05% BSA, 0.03% Proclin 300 |
Stability & Storage | 12 months from date of receipt / reconstitution, -20 °C as supplied |
Dilution
application | dilution | species |
IHC-P | 1:500 | null |
IF | 1:1000 | null |
Background
Cadherin 17 is a member of a multigene family of calcium-dependent, transmembrane proteins that mediates cell-cell adhesion, plays important roles during embryogenesis, and is crucial for tissue morphogenesis and maintenance. Cadherin 17 is exclusively expressed in the epithelial cells of embryonic and adult small intestine and colon, and pancreatic ducts. It has also been reported to be frequently expressed in adenocarcinomas arising in the gastrointestinal tract and pancreas. Owing to its restricted expression in these groups of tumors, cadherin 17 has proven to be a useful immunohistochemical marker for assisting in distinguishing these neoplasms from other malignancies with which they may be confused [PMID: 24508695].
Picture
Picture
Immunohistochemistry




Immunofluorescence

IF shows positive staining in paraffin-embedded human colon. Anti-Cadherin 17 antibody was used at 1/1000 dilution (Green) and incubated overnight at 4°C. Goat polyclonal Antibody to Rabbit IgG - H&L (Alexa Fluor® 488) was used as secondary antibody at 1/1000 dilution. Counterstained with DAPI (Blue). Heat mediated antigen retrieval with Tris/EDTA buffer pH9.0 was performed before commencing with IF staining protocol.

Negative control:IF shows negative staining in paraffin-embedded human skeletal muscle. Anti-Cadherin 17 antibody was used at 1/1000 dilution and incubated overnight at 4°C. Goat polyclonal Antibody to Rabbit IgG - H&L (Alexa Fluor® 488) was used as secondary antibody at 1/1000 dilution. Counterstained with DAPI (Blue). Heat mediated antigen retrieval with Tris/EDTA buffer pH9.0 was performed before commencing with IF staining protocol.